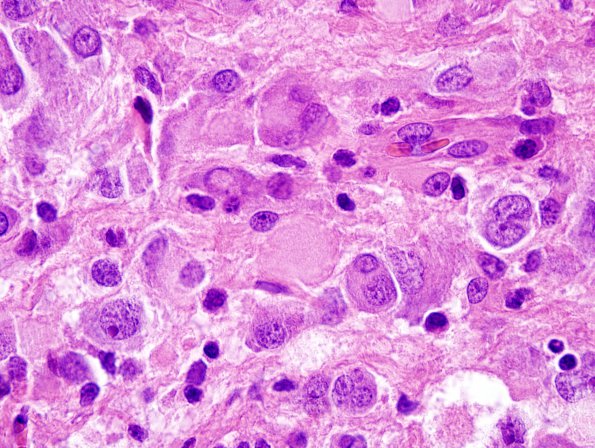
2C8 DIG (Case 2) H&E 100X 1

Table of Contents
Washington University Experience | NEOPLASMS (NEURONAL) | Desmoplastic Infantile Ganglioglioma (DIG) | 2C8 DIG (Case 2) H&E 100X 1
Numerous scattered atypical ganglion cells with marked cell size variation and multinucleation accompany abundant neuritic spheroids are also present in these areas. (H&E)